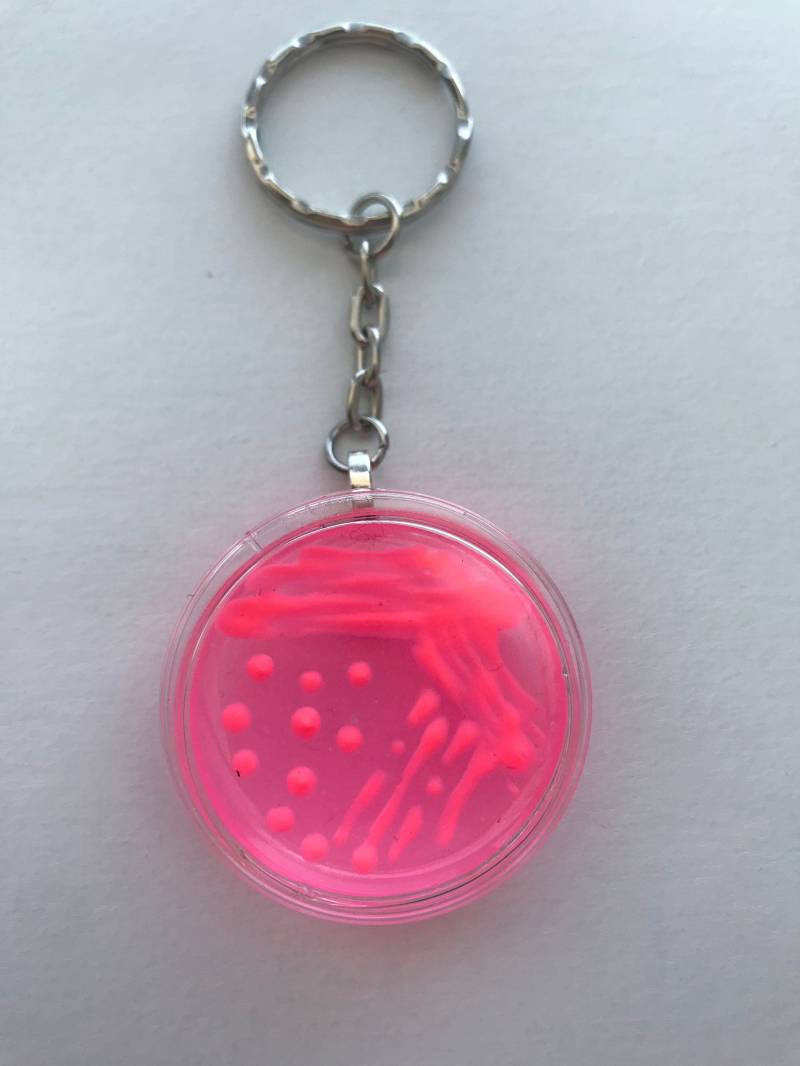

E.coli Mac Petrischale Schlüsselanhänger/Mikrobiologie Agar Kunst Bakterien Science Lab Geschenk Wissenschafts
ShopMicrobi
9,61 €
Farbe: Rosa
Versand: 10,77 €
Versand: 10,77 €
gefunden bei Etsy
Beschreibung:
E.coli (neon pink) Bakterien auf MacConkey (pink) Agar Dieser Mikrobiologie-Schlüsselanhänger ist von Hand gefertigt und zeigt E.coli-Bakterien auf MacConkey-Agar. Das Bakterium (Streifen oben) ist neon pink, und die Basis (Boden) ist pink. Die Abmessungen der Petrischale sind 35 mm. Behälter ist eine echt Plastik Zellkulturschale. Designs sind realistisch und genau. Unsere Schlüsselanhänger werden nicht mehr mit einer lernfähigen Trägerkarte geliefert! Ich verkaufe verschiedene Optionen von Schlüsselanhängern, bitte sehen Sie meine anderen Angebote an! Wenn Sie nicht sehen, was Sie suchen, schreiben Sie mir für benutzerdefinierte Optionen! HINWEIS: Es kann zu Abweichungen in Farbe / Muster kommen, da alle Artikel handgefertigt werden! Das sind keine echten Bakterien. Alle Schlüsselanhänger sind aus Bastelmaterialien hergestellt. Kontakt für Mengenrabatte oder für lokale Abholungen innerhalb des GTA. E.coli Mac Petrischale Schlüsselanhänger/Mikrobiologie Agar Kunst Bakterien Science Lab Geschenk Wissenschafts
E.coli (neon pink) Bakterien auf MacConkey (pink) Agar Dieser Mikrobiologie-Schlüsselanhänger ist von Hand gefertigt und zeigt E.coli-Bakterien auf MacConkey-Agar. Das Bakterium (Streifen oben) ist neon pink, und die Basis (Boden) ist pink. Die Abmessungen der Petrischale sind 35 mm. Behälter ist eine echt Plastik Zellkulturschale. Designs sind realistisch und genau. Unsere Schlüsselanhänger werden nicht mehr mit einer lernfähigen Trägerkarte geliefert! Ich verkaufe verschiedene Optionen von Schlüsselanhängern, bitte sehen Sie meine anderen Angebote an! Wenn Sie nicht sehen, was Sie suchen, schreiben Sie mir für benutzerdefinierte Optionen! HINWEIS: Es kann zu Abweichungen in Farbe / Muster kommen, da alle Artikel handgefertigt werden! Das sind keine echten Bakterien. Alle Schlüsselanhänger sind aus Bastelmaterialien hergestellt. Kontakt für Mengenrabatte oder für lokale Abholungen innerhalb des GTA. E.coli Mac Petrischale Schlüsselanhänger/Mikrobiologie Agar Kunst Bakterien Science Lab Geschenk Wissenschafts
Zum Shop
Love it
Hate it
Kommentare: 0
Votes: 0
Ähnliche Produkte

16,68 €jewelwill
Echte Solid 925 Sterling Silver Doppel Herzen Valentine Charme/Anhänger
gefunden bei Etsy

9,99 €European League Of Football
European League Of Football Blanko Baumwoll-Hoodies antikweiß
gefunden bei Outlet46

1,60 €Joom DACH
10 Stück Schaft-Nähknöpfe, runde flache Form, Metallknöpfe, Windjacke, Mantel, Hemd, Knopf 10mm gold
gefunden bei Joom DACH

14,99 €11,99 €erised's bifrost
erised's bifrost Mini Faltender Regenschirm Freien UV Schutz,kreativer Ringgriff,Sonnenschutz Klein für Koffer Taschenschirm,Beschichtung Gegen Feuchtigkeitsschäden für Damen und Kinder Reise
gefunden bei Amazon Marketplace


Passende Looks von Nutzern
legoli
am 11.04.2014
Wie gefällt euch mein Look?
Kommentare7

Lia95
am 22.04.2014
Sieht toll aus! Echt chic. :)

Bravo-Girl-12
am 14.04.2014
wow du hast ja lange beine

legoli
am 12.04.2014
Tally @ThisIsMe.

ThisIsMe.
am 11.04.2014
Super :)
Woher ist das oberteil?

catfood
am 11.04.2014
Schöne Figur :) aber ich glaub eine hellblaue jeans würde besser dazu passen :)

legoli
am 11.04.2014
Dankee ☺️

Jessy.
am 11.04.2014
Sehr hübsch!!





 Accessoires
Accessoires Baby
Baby Jungen
Jungen Mädchen
Mädchen Spielzeug
Spielzeug



